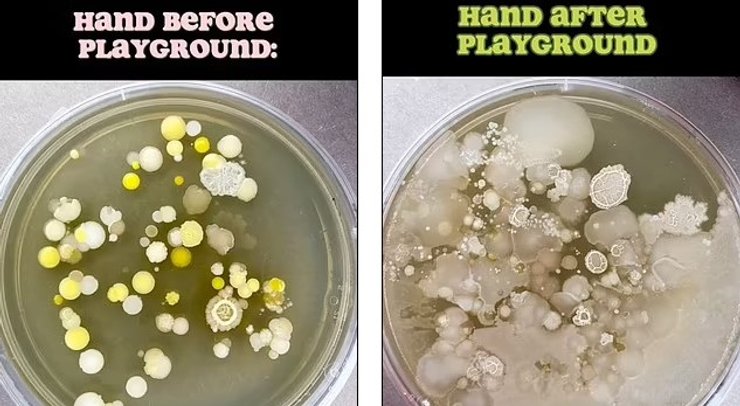
Чашка Петрі до і після відвідування дитячого майданчика

Тисячі бактерій на долоньках. Учений розповів усю неприємну правду про дитячі майданчики (фото)

Мікробіолог поділився результатами перевірки дитячих ігрових майданчиків, і вони виглядають вельми тривожно.
Похід на ігровий майданчик має вельми привабливий вигляд для дитини, проте результати перевірки дитячих майданчиків показали вельми тривожні результати — це може бути небезпечніше, ніж ми вважали раніше, пише Daily Mail.
32-річний мікробіолог з Юти Тім Колл поділився тривожними висновками після перевірки того, наскільки чистими насправді є ігрові майданчики. На жаль, результати мають вельми тривожний вигляд: на дитячих долонях виявили тисячі бактерій лише після години, проведеної на дитячому майданчику.
У Фокус. Технології з'явився свій Telegram-канал. Підписуйтесь, щоб не пропускати найсвіжіші та найзахопливіші новини зі світу науки!
Зазначимо, Колл часто проводить подібні перевірки для всього від сушарок для рук і кухонних раковин. Як правило, мікробіолог зосереджується на широко використовуваних предметах і приміщеннях. У своєму новому дослідженні він зосередився на перевірці дитячого ігрового майданчика в парку, порівнявши кількість бактерій на долонях дітей до і після години на ігровому майданчику.
Мікробіолог почав свій експеримент із того, що перевірив долоні дитини до відвідування майданчика на чашці Петрі. Лише через 10 хвилин він виявив кілька колоній бактерій. Потім дитина грає годину на дитячому майданчику, використовуючи іграшкове каміння, гірки та різні тріски навколо.
Після цього дитина кладе руку в іншу чашку Петрі, яку потім досліджував мікробіолог. Результати показують, що лише через годину перебування на дитячому майданчику на долонях малюка виявлено тисячі колоній бактерій, а також великі ділянки грибка.
За словами самого Колла, йому захотілося дослідити дитячий майданчик, щоб продемонструвати, що бактерії є всюди. Також мікробіологу здалося, що вибір саме цього місця виявиться вельми цікавим. Утім, він не помилився.
Автор дослідження також зазначає, що його метою була демонстрація величезного зросту після відвідування місця з інтенсивним рухом транспорту. Колл також сподівається, що результати цього експерименту змусять людей відповідальніше ставитися до гігієни й мити руки після відвідування подібних місць. Вчений каже, що результати експерименту зовсім не стали для нього несподіванкою: насправді він очікував побачити велике зростання бактерій і виявив саме те.
До речі, найчистішим місцем з усіх, які коли-небудь доводилося тестувати Коллу, виявилися бензоколонки на заправних станціях. Науковець зазначає, що очікував виявити на них тисячі бактерій через їхнє часте використання, проте був здивований, виявивши лише невелике зростання — лише 5 колоній бактерій.
Раніше Фокус писав про те, що вчені розповіли всю неприємну правду про купання в джакузі.